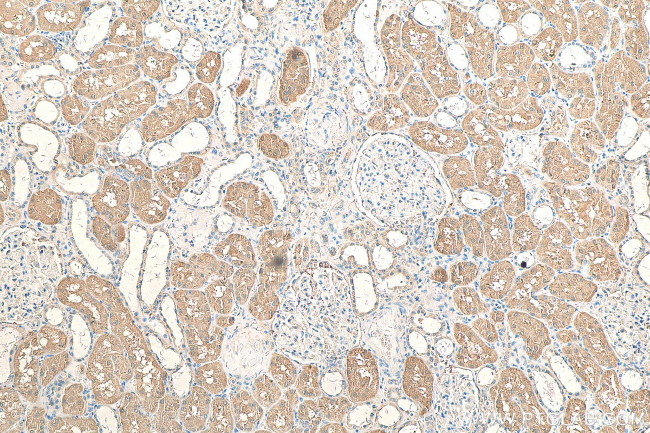
C2orf47 Antibody in Immunohistochemistry (Paraffin) (IHC (P))
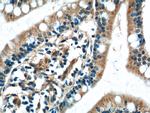
C2orf47 Antibody in Immunohistochemistry (Paraffin) (IHC (P))

Search
Proteintech
C2orf47 Polyclonal Antibody
{{$productOrderCtrl.translations['antibody.pdp.commerceCard.promotion.promotions']}}
{{$productOrderCtrl.translations['antibody.pdp.commerceCard.promotion.viewpromo']}}
{{$productOrderCtrl.translations['antibody.pdp.commerceCard.promotion.promocode']}}: {{promo.promoCode}} {{promo.promoTitle}} {{promo.promoDescription}}. {{$productOrderCtrl.translations['antibody.pdp.commerceCard.promotion.learnmore']}}
产品信息
24930-1-AP
种属反应
宿主/亚型
分类
类型
抗原
偶联物
形式
浓度
规格
纯化类型
保存液
内含物
保存条件
运输条件
产品详细信息
Immunogen sequence: MALAARLLP QFLHSRSLPC GAVRLRTPAV AEVRLPSATL CYFCRCRLGL GAALFPRSAR ALAASALPAQ GSRWPVLSSP GLPAAFASFP ACPQRSYSTE EKPQQHQKTK MIVLGFSNPI NWVRTRIKAF LIWAYFDKEF SITEFSEGAK QAFAHVSKLL SQCKFDLLEE LVAKEVLHAL KEKVTSLPDN HKNALAANID EIVFTSTGDI SIYYDEKGRK FVNILMCFWY LTSANIPSET LRGASVFQVK LGNQNVETKQ LLSASYEFQR EFTQGVKPDW TIARIEHSKL LE (1-291 aa encoded by BC017959)
靶标信息
Promotes sorting of SMDT1/EMRE in mitochondria by ensuring its maturation. Interacts with the transit peptide region of SMDT1/EMRE precursor protein in the mitochondrial matrix, leading to protect it against protein degradation by YME1L1, thereby ensuring SMDT1/EMRE maturation by the mitochondrial processing peptidase (PMPCA and PMPCB).
仅用于科研。不用于诊断过程。未经明确授权不得转售。
生物信息学
蛋白别名: m-AAA protease-interacting protein 1, mitochondrial; Matrix AAA peptidase-interacting protein 1; uncharacterized protein C2orf47 homolog, mitochondrial; unnamed protein product
基因别名: AA409999; C2orf47; C78988; MAIP1
UniProt ID: (Mouse) Q8BHE8, (Human) Q8WWC4
Entrez Gene ID: (Mouse) 68115, (Human) 79568